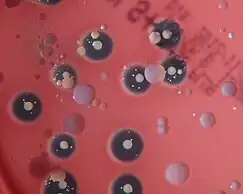

| Actinobacillus equuli | |
|---|---|
| Scientific classification | |
| Domain: | Bacteria |
| Phylum: | Pseudomonadota |
| Class: | Gammaproteobacteria |
| Order: | Pasteurellales |
| Family: | Pasteurellaceae |
| Genus: | Actinobacillus |
| Species: | A. equuli |
| Binomial name | |
| Actinobacillus equuli (van Straaten, 1918) Haupt, 1934 | |
Actinobacillus equuli is a gram-negative, non-motile rod bacteria from the family Pasteurellaceae.[1]
A. equuli is classified as a bio-containment level 2 organism under the U.S. Public Health Service Guidelines.[2] Biochemical differentiation tests with positive results are: catalase, urease and oxidase tests. Actinobacillus equuli subspecies equuli is not hemolytic and is found in equine and porcine hosts. Another subspecies exists and is classified as Actinobacillus equuli subsp. haemolyticus which is positive for hemolysis and is found in horses and very rarely in rabbits.[3][4] Occasionally, humans can become infected with A. equuli, more commonly as a result from destruction to the skin barrier, such as a horse bite.[5]
A. equuli can commonly be isolated from the upper respiratory tract and oral cavity of adult healthy horses and can be important for diseases of foals, adult horses and pigs.[6] It is a commensal bacteria unless it multiplies to overwhelming numbers, at which point it will cause disease. Specifically, A. equuli is known to cause neonatal sepsis in foals, known as Sleepy Foal Disease. Less commonly, A. equuli will cause disease in adult horses, resulting in respiratory infections.[3] A. equuli also has the capability to cause kidney damage, arthritis and septicemia in affected pigs.[7] The subspecies A. equuli subsp. haemolyticus results in similar pathogenesis as A. equuli subsp. equuli in horses. Due to these diseases and conditions, A. equuli can result in great economic losses especially in the equine industry.
Taxonomy and genome
Taxonomy
It was previously thought that this bacteria was limited to the species level, however it is now divided into two subspecies of Actinobacillus equuli which include: A. equuli subsp. equuli, and A. equuli subsp. haemolyticus.[1][8] Differentiation between these two subspecies can be done via biochemical tests including a CAMP test, and haemolytic properties. A. equuli subsp. equuli is non-haemolytic and CAMP negative, while A. equuli subsp. haemolyticus is haemolytic and CAMP positive.[8]
| Subspecies | Biochemical test | Result |
|---|---|---|
| equuli | CAMP
Haemolytic |
(-)
(-) |
| haemolyticus | CAMP
Haemolytic |
(+)
(+) |
Isolation of the subspecies equuli have been found in both horses and pigs, but only subspecies haemolyticus has been isolated from horses.[8]
Genome
Actinobacillus equuli genome's size is approximately 1.7 GDa and contains 40% guanine and cytosine in its genetic makeup.[9]
A. equuli type strains include: ATCC 19392, CCUG 2041, GIP 103284, DSM 19655, JCM 2432, LMG 3736, and NCTC 8529.[10] The 16S rRNA gene for A. equuli is AF381186, this helps classification of the bacteria to the species level but not to the subspecies level.[10] This information helped determine that this species is closely related to Actinobacillus suis and Actinobacillus hominus.[11] Another 16s rRNA study determined that an A. equuli type strain was 98.3% similar to A. lignieresii but are of different species.[12]
Isolation of the subspecies equuli in the UK and Australia determined that it contained strains NCTC 8529T, and I 5445/4. A. equuli subspecies haemolyticus contain strains: T 355/87, F 92, Ac 7 F 119, F 154T, and F 490.[9] PCR testing that results in the presence of the RTX gene allows differentiation to be made between the two subspecies, as only A. equuli subsp. equuli contains the RTX gene.[13]
To differentiate similar strains of A. equuli from other genera originally thought to be A. equuli, ribotyping can be performed. The characteristic of being L-arabinose positive was thought to be an important taxonomic characteristic to classify A. equuli strains from others.[14] Many different strains of A. equuli were determined through ribotyping, indicating that this species is diverse.
Epidemiology
Horses
A. equuli is found on a variety of mucosal surfaces in the horse; it is considered to be part of the normal flora and an opportunistic pathogen.[15] Despite it being a component of the normal flora, an mean isolation frequency as low as 37% (n =174) in adult horses and foals was detected in one study.[16] However, the isolation frequency varied from 12 to 88% between farms.[16] A. equuli does not have a preference for age, breed or gender,[17] suggesting that husbandry practices may play a role in isolation frequency.[16] An important aspect of the isolation frequency is that a horse or foal will not be culture positive every time it is swabbed, making it hard to determine the correct isolation frequency.
A. equuli is the causative agent in sleepy foal syndrome, which has been documented throughout the world.[4] It is important to note that A. equuli does not only cause sleepy foal syndrome in foals, it is also a causative agent of pneumonia, muscular degeneration and jaundice in foals. On necropsy, foals were found to have the highest distribution of the bacteria in their synovial fluid, followed by the thoracic fluid and the liver.[9] Important risk factors for foals acquiring an infection with A. equuli include failure of passive transfer, unsanitary foaling environments, and the presence of immunosuppressive conditions.[9] Foals can become infected in-utero, during parturition or shortly after birth.[18] Adults horses have similar diseases associated with A. equuli infections, including septicemia, respiratory and bone/joint diseases.[19] Less common forms of infection can manifest as cutaneous abscess, pharyngitis, guttural pouch eustachitis, pericarditis, mastitis, urethritis, and lymphadenitis.[19] Risk factors for developing infections in adult horses differs from that of foals, these factors include: stress, concurrent bacterial and/or viral infections, and discontinuities in the mucosa membranes allowing the bacteria entry into the body's internal compartment.[19]
Swine
Infections in swine are more common in European countries compared to the North American Countries.[13] Infections in the United States are extremely rare with only 2 cases reported prior to 2008 and there was a 30-year period leading up to 2008 in which there were no cases documented.[13] There has only ever been one case reported in Manitoba, Canada in 2010.[7] However, infections may have occurred but were unreported. An infection with A. equuli in swine commonly yields septicemia, metritis, and can result in abortion. It was once thought pigs acquired the infection directly from horses, but there has been reports of swine developing infections on farms that housed horses prior to housing swine, and there has also been one case in which the swine infected had no association with horses.[7] Owing to the fact that the exact source of the infection in swine is not known, the risk factors are also relativity unknown.[7]
Microbiology
Morphology and culture growth
Actinobacillus equuli are rod-shaped bacteria that measure an average of 1 μm in length.[20] According to a study of the complete genome of A. equuli, this microbe can be cultured on blood agar at an optimal temperature of 37 °C, but is able to grow in temperatures ranging from 20 °C to 44 °C.[21] Two studies noted that the colonies of A. equuli are circular, smooth in texture and produce a slimy, viscous material that gives the colonies a gelatinous and glossy appearance.[21][22] In addition to its mesophilic properties, A. equuli can grow at a pH of 6.0 to 8.4 which allows the organism to inhabit the intestine and survive in various structures such as the heart and adrenal gland.[3][23] A. equuli is a facultative anaerobe and is moderately fastidious, therefore culture growth in the laboratory may be challenging.
Biochemical tests
As part of the genus Actinobacillus, Actinobacillus equuli is gram negative.[1] A. equuli displays negative results after inoculation into motility agar indicating a lack of motility.[22] A. equuli is equipped with catalase and urease enzymes and therefore yield positive results for these tests. Although facultatively anaerobic, A. equuli can survive in environments exposed to oxygen as it contains the enzyme cytochrome oxidase for use in the electron transport chain.[3][24] Differentiation between A. equuli subsp. equuli and A. equuli subsp. haemolyticus can be made using sheep's blood agar or the CAMP test upon the absence or presence of beta-haemolysis, respectively.[3][25]
A. equuli has varying results for sugar fermentation. A. equuli subsp. equuli is not capable of fermenting cellobiose, whereas the opposite is true for A. equuli subsp. haemolyticus, indicated by a negative and positive result for the cellobiose fermentation test, respectively. However, both subspecies are positive for lactose fermentation,[22] which is indicated by using phenol red lactose broth. Gram negative lactose fermenters typically display positive results on MacConkey agar, however, a study on equine actinobacilli resulted in the lack of growth on MacConkey agar,[22] which may suggest that A. equuli is too fastidious to grow on this medium. To add, A. equuli ferments D-glucose as indicated by a positive result for the oxidative-fermentation glucose test performed using Hugh-Leifson medium.[22][26] Both subspecies yield a positive result for both raffinose and D-galactose fermentation[3][22] and displays mixed results for D-mannitol fermentation, where only some biovars of A. equuli subsp. haemolyticus displayed a negative result while others were positive for D-mannitol fermentation.[22]
A. equuli is negative for the methyl red test, which indicates that this microbe does not use the mixed acid fermentation pathway.[24] A. equuli also displays a negative Voges-Proskauer test because A. equuli does not use the 2,3-butanediol fermentation pathway resulting in the absence of acetoin production.[20][24] As demonstrated by a negative Simmon's citrate test result, A. equuli is not able to use citrate as its sole carbon source for energy.[22]
| Biochemical Test | Test Result |
|---|---|
| Gram Stain | - |
| Motility Agar | - |
| Catalase | + |
| Urease | + |
| Oxidase | + |
| Sheep's Blood Agar | A. equuli subsp. equuli: γ-haemolysis
A. equuli subsp. haemolyticus: β-haemolysis |
| CAMP | A. equuli subsp. equuli: -
A. equuli subsp. haemolyticus: + |
| Cellobiose Fermentation | A. equuli subsp. equuli: -
A. equuli subsp. haemolyticus: + |
| Lactose Fermentation | + |
| MacConkey Agar | No growth |
| Oxidative/Fermentation Glucose | +, absent gas production |
| Raffinose Fermentation | + |
| D-galactose Fermentation | + |
| D-mannitol Fermentation | A. equuli subsp. equuli: +
A. equuli subsp. haemolyticus: +/- |
| Methyl Red | - |
| Voges-Proskauer | - |
| Simmon's Citrate | - |
Pathogenesis
Horses
The major host for A. equuli is horses and under physiological conditions, A. equuli is part of horses' mucosal microbiota and does not normally cause clinical symptoms and/or lesions.[3] However, when mucous membranes become compromised (wound penetration, ulcers/erosions) it allows for resident A. equuli to establish infection in the horses' internal environment. A. equuli's penetration into the body's internal environment has been reported to cause septicemia in newborn foals (also called sleepy foal disease) and localized infections in adult horses or in more severe cases acute or chronic peritonitis.[27] It is unknown at this time if there are certain strains of A. equuli that have a greater virulence for adult horses and/or foals.
One study emphasized the contribution of A. equuli to the development of equine valvular endocarditis, where an isolate grown from the bacterial samples of an vegetative equine heart showed stunning resemblance with the phenotypical characteristics of a pure culture of A. equuli subsp. equuli. Although the exact source of infection is not yet known for horses with valvular endocarditis, it has been suggested that this microbe may be distributed through the body by the migration of Strongylus vulgaris,[3] a common pasture parasite that inhabits the intestinal mucosa of horses and can migrate intravascularly to various organs of the body.[28]
The pathogenicity and virulence factors of A. equuli are not well known, but following PCR analysis it has been determined that both subspecies (equuli and haemolyticus) have the RTX toxin gene which is capable of causing host species specific toxicity.[29]
Swine
A. equuli has been found occasionally to cause disease in sows and their piglets however, like in horses, the pathogenicity is not well known.[7] Unlike horses, PCR analysis did not find the aqxA gene and therefore concluded that only subspecies equuli and not subspecies haemolyticus causes disease in pigs.[7][13][30][31] In sows, A. equuli is thought to cause disease as both a primary and a secondary pathogen.[7][13] In piglets, since they usually show clinical signs within hours up to 4 days after parturition, it is hypothesized that the piglets are infected in utero.[7][30] Nasal, fecal and vaginal swabs of infected sows were performed and pure cultures of A. equuli were only found in the vaginal swabs, supporting the hypothesis of in utero infection.[30] Navel swabs and blood tests were performed on affected piglets and no A. equuli was cultured and bacteremia was not found.[30] The pathogenicity causing the variation in clinical manifestations between cases of swine affected with A. equuli is not well understood.
The virulence factors of A. equuli in swine is also not well known.[30]
Rabbits
There has been one case that found a rabbit presenting for necropsy, had a secondary infection caused by A. equuli.[4] The rabbit was diagnosed with acute hepatitis characteristic of Tyzzer's disease caused by Clostridium piliforme. However, samples of the lungs and liver of the rabbit also resulted in the culture of A. equuli subspecies haemolyticus. A. equuli was determined to be a secondary opportunistic invader in this rabbit.[4]
Clinical signs
Horses
Acute signs: moderate to severe abdominal pain (colic), inappetence, intestinal stasis, lethargy.[27]
Chronic signs: weight loss
Less frequently A. equuli has also been known to cause respiratory tract disease, abortion, haemorrhagic diatheses, pericarditis, periorchitis, enteritis, and peritonitis.[32]
Sleepy foal syndrome: The acute form of sleepy foal syndrome presents as sepsis that can lead to death. Acutely infected foals appear dull, can have pneumonia and are neutropenic. However, in some cases a chronic form of the disease can manifest in the kidneys, lungs, and joints resulting in lesions to the affected areas.[21][33]
Necropsies of horses infected with A. equuli showed consistent diffuse, bilateral, multifocal renal infarcts affecting the renal cortices. Fibrinous exudate and pulmonary edema was also a common finding.[34]
Swine
Acute Signs in sows: Most commonly lethargy, inappetence, sudden death.[7][13] Less commonly causes recumbency, hyperesthesia,[7] pneumonia, bronchitis, surface wound infections,[35] metritis, and septicemia.[13]
Acute signs in piglets: lethargy, +/- pyrexia, severe arthritis (causing them to be non-weight bearing on that limb),[7][30] encephalitis (although only neurological signs were lateral recumbency), septicemia and sudden death.[7][30]
Chronic signs of piglets and sows: Poor doing and weight loss leading to culling or euthanasia[7]
Sow Necropsies: Sows most commonly had dehydration, subcutaneous hemorrhage, embolic infarcts consisting of neutrophils and basophilic bacilli in the renal cortex.[7][13] Embolic infarcts were also found in liver, lungs spleen, adrenal gland.[7][13] Sows were concluded to have died of renal infarcts.
Gilt Necropsy: A gilt was found to have liquefactive necrosis in the epicardium of both auricles of the heart, valvular endocarditis of both mitral and tricuspid valves and thrombus of the right atrial wall.[13] She had recently aborted her pregnancy and within the amniotic sacs of the aborted fetuses, a brown serous fluid was found. The gilt was concluded to have died of A. equuli causing valvular endocarditis and metritis with secondary septicemia.[13]
Piglet Necropsies (6 hours to 4 days old belonging to infected sows): Piglets had petechial hemorrhage and multiple bacterial emboli in the renal cortex +/- multifocal purulent nephritis.[7][30] Piglets were also found to have severe diffuse fibrinopurulent arthritis in one or more joints.[7][30] Some piglets have additionally had a mild purulent encephalitis and perivasculitis of the vessels in the brain.[30]
Prevention and treatment
Horses
A. equuli causing sleepy foal syndrome in neonatal horses is most often attributed to the mother, as A. equuli is part of the normal microflora of the mare which makes it difficult to prevent exposure of the foal to A. equuli. [36][37] In a majority of reported cases, sleepy foal syndrome is more than likely a direct result of failure of passive transfer thus, it is important that neonatal foals receive colostrum to reduce the incidence of the disease caused by A. equuli.[38] Reducing environmental contamination when the foal is born has also shown to be effective at reducing the incidence of disease.[33] In adult horses, there has been a reported case of infection caused by A. equuli associated with gastrointestinal ulceration possibly due to the use of phenylbutazone for extended periods of time. Ulceration of the GI mucosa can allow A. equuli to set up an opportunistic infection. Limiting the duration or dose of phenylbutazone could reduce the chance of ulceration and thus an infection.[27] Preventative treatments can also include minimizing the risk of infection with other parasites or pathogens that could weaken the immune system or cause physical damage that allows A. equuli to set up an infection. Some studies have found that A. equuli infections have been established after exposure with Strongylus vulgaris as the migrating larvae can transport A. equuli to various parts of the body resulting in infection.[27] Overall, ensuring the health of the horse is maintained has shown to be the best strategy to reduce infection with A. equuli.
Treatment and supportive care of a horses infected with A. equuli has been shown to be very effective when detected early, resulting in low incidence of death associated with infection.[39] One study involving 51 horses with peritonitis associated with A. equuli, found treatment with procaine penicillin or procaine penicillin and gentamicin sulphate to be effective. However, antimicrobial sensitivity testing of 14 cultures showed 1 culture to be resistant to penicillin, 1 resistant to trimethoprim-sulphadimidine and 1 resistant to a combination of penicillin and trimethoprim-sulphadimidine. Thus the study recommended the treatment with procaine penicillin and gentamicin sulphate in cases of antimicrobial resistance.[32] In neonatal foals with sleepy foal syndrome, treatment failure resulting in fatal outcome has been recorded because of the severity of the condition and an inability of the neonate to successfully mount an immune response against the pathogen due to failure of passive transfer.[33] In other cases, treatment of sleepy foal syndrome included antibiotic treatment with amoxicillin-clavulanic acid and amikacin sulfate along with fluid therapy.[40]
Swine
During the outbreak at the swine farm in Canada, both preventative antibiotic therapy in the water and feed of the entire herd and individual therapy of the clinically affected sows was administered.[7] Susceptibility testing showed that A. equuli was sensitive to ampicillin, tetracycline, trimethoprim, ceftiofur, neomycin and spectinomycin. Clinically affected sows were determined by failure to rise when stimulated and temperature, and were additionally treated with antibiotics and anti-inflammatories.[7] Some of the clinically affected sows who survived the initial infection were euthanized or culled due to wasting and poor-doing. Sow mortality ranged from an average of 8 deaths per day at the beginning of the outbreak, to 2 deaths/day by day 50 of the infection.
Prevention of A. equuli spread in swine operations with herd outbreak from the infected to the non-infected sows or newly introduced gilts was mitigated by the development of a herd-specific killed vaccine.[7][30][31]
Zoonotic potential
A. equuli commonly affects equine hosts. Occasionally, A. equuli has been found to cause disease in sows and their newborn piglets.[7][30][13] There was one case describing a rabbit who was infected with A. equuli. [4]
Humans have also been found to have infections caused by A. equuli after being bit by a horse. One case study described a stable hand who had been bitten by a horse 12 hours prior, presenting to the hospital with a red and swollen laceration on the dorsal side of his hand. A. equuli-like species was cultured from the wound and was determined to cause the infection along with A. lignieresii.[41] Additionally, there has been one case of a 13-year-old boy who developed meningitis and sepsis from A. equuli.[5] The boy had visited a farm 3 days prior but denied coming into direct contact with horses or pigs.[5] Furthermore, a blood sample from a 53 year old butcher with septicemia was found to contain A. equuli after the individual had lacerated his left thumb. Prior to the discovery, A. equuli had never been recorded in the blood of a human with septicemia.[42]
Susceptibility and resistance
Susceptibility testing performed found that A. equuli was sensitive to ampicillin, tetracycline, trimethorprin, ceftiofur, neomycin, cefotaxime, ceftazidime, imipenem, meropenem, ciprofloxacin, levofloxacin, piperacillin-tazobactam, tigecycline and spectinomycin.[5][7]
However, after conducting susceptibility testing, one study found A. equuli resistance to penicillin, ampicillin, streptomycin, neomycin, chloramphenicol, methicillin, and nalidixic acid. The study also found susceptibility of A. equuli to gentamicin, tetracycline, nitrofurantoin, polymyxin B, sulphonamides, trimethoprim with sulphonamides, carbenicillin, cephalotin, and amoxycillin with clavulanic acid. The study did note it had differing results in susceptibility tests than other studies had reported, which could be a result of regional or strain differences or differences in the methods of the susceptibility testing between studies.[43] Additional reports have found A. equuli resistance to oxacillin and trimethoprim-sulphadimidine along with developed resistance to tetracycline after one month of use in sows.[7][32][44]
References
- 1 2 3 Berthoud, H.; Frey, J.; Kuhnert, P. (2002-06-20). "Characterization of Aqx and its operon: the hemolytic RTX determinant of Actinobacillus equuli". Veterinary Microbiology. 87 (2): 159–174. doi:10.1016/S0378-1135(02)00048-2. ISSN 0378-1135. PMID 12034544.
- ↑ "Actinobacillus equuli subsp. equuli (van Straaten) Haupt ATCC ® 19". www.atcc.org. Retrieved 2020-11-04.
- 1 2 3 4 5 6 7 8 Aalbæk, B.; Østergaard, S.; Buhl, R.; Jensen, H.E.; Christensen, H.; Bigaard, M. (2007). "Actinobacillus equuli subsp. equuli associated with equine valvular endocarditis". APMIS. 115 (12): 1437–1442. doi:10.1111/j.1600-0463.2007.00768.x. PMID 18184417. S2CID 41369747 – via Wiley Online Library.
- 1 2 3 4 5 Moyaert, H.; Decostere, A.; Baele, M.; Hermans, K.; Tavernier, P.; Chiers, K.; Haesebrouck, F. (2007-09-20). "An unusual Actinobacillus equuli strain isolated from a rabbit with Tyzzer's disease". Veterinary Microbiology. 124 (1): 184–186. doi:10.1016/j.vetmic.2007.04.013. hdl:1854/LU-416303. ISSN 0378-1135. PMID 17482388.
- 1 2 3 4 Montagnani, Carlotta; Pecile, Patrizia; Moriondo, Maria; Petricci, Patrizia; Becciani, Sabrina; Chiappini, Elena; Indolfi, Giuseppe; Rossolini, Gian Maria; Azzari, Chiara; de Martino, Maurizio; Galli, Luisa (June 2015). Patel, R. (ed.). "First Human Case of Meningitis and Sepsis in a Child Caused by Actinobacillus suis or Actinobacillus equuli". Journal of Clinical Microbiology. 53 (6): 1990–1992. doi:10.1128/JCM.00339-15. ISSN 0095-1137. PMC 4432038. PMID 25878346.
- ↑ Rycroft, A. N.; Garside, L. H. (January 2000). "Actinobacillus species and their role in animal disease". Veterinary Journal. 159 (1): 18–36. doi:10.1053/tvjl.1999.0403. ISSN 1090-0233. PMID 10640409.
- 1 2 3 4 5 6 7 8 9 10 11 12 13 14 15 16 17 18 19 20 21 22 23 Thompson, Amy B.; Postey, Rosemary C.; Snider, Tim; Pasma, Tim (November 2010). "Actinobacillus equuli as a primary pathogen in breeding sows and piglets". The Canadian Veterinary Journal. 51 (11): 1223–1225. ISSN 0008-5286. PMC 2957028. PMID 21286321.
- 1 2 3 Henrik Christensen; Magne Bisgaard; John Elmerdahl Olsen (2002-09-01). "Reclassification of equine isolates previously reported as Actinobacillus equuli, variants of A. equuli, Actinobacillus suis or Bisgaard taxon 11 and proposal of A. equuli subsp. equuli subsp. nov. and A. equuli subsp. haemolyticus subsp. nov". International Journal of Systematic and Evolutionary Microbiology. 52 (5): 1569–1576. doi:10.1099/00207713-52-5-1569. ISSN 1466-5026. PMID 12361259.
- 1 2 3 4 Kamada M., et al. “Isolation of Actinobacillus Equuli from Neonatal Foals with Death in Colostrum-Deficiency or Failure of Maternal Immunity Transfer.” Bulletin of Equine Research Institute, 1985, pp. 38–42.
- 1 2 "Species: Actinobacillus equuli". lpsn.dsmz.de. Retrieved 2020-10-28.
- ↑ Huang, Barbara F; Kropinski, Andrew M; Bujold, Adina R; MacInnes, Janet I (2015-06-07). "Complete genome sequence of Actinobacillus equuli subspecies equuli ATCC 19392T". Standards in Genomic Sciences. 10 (1): 32. doi:10.1186/s40793-015-0009-x. ISSN 1944-3277. PMC 4511653. PMID 26203343.
- ↑ Nørskov-Lauritsen, Niels; Christensen, Henrik; Okkels, Henrik; Kilian, Mogens; Bruun, Brita (2004-05-01). "Delineation of the genus Actinobacillus by comparison of partial infB sequences" (PDF). International Journal of Systematic and Evolutionary Microbiology. 54 (3): 635–644. doi:10.1099/ijs.0.02785-0. ISSN 1466-5026. PMID 15143001.
- 1 2 3 4 5 6 7 8 9 10 11 12 Ramos-Vara, J. A.; Wu, C. C.; Mitsui, I.; Lin, T. L.; Miller, M. A. (2008-07-01). "Metritis, Valvular Endocarditis, and Septicemia by Actinobacillus equuli in a Gilt in the United States". Veterinary Pathology. 45 (4): 495–499. doi:10.1354/vp.45-4-495. PMID 18587096. S2CID 207268778.
- ↑ Blackall, PJ; Christensen, JP; Bisgaard, M (June 1998). "Diversity among isolates of Actinobacillus equuli and related organisms as revealed by ribotyping". Australian Veterinary Journal. 76 (6): 423–425. doi:10.1111/j.1751-0813.1998.tb12394.x. PMID 9673769. Retrieved November 30, 2020.
- ↑ Donahue, James M.; Sells, Stephen F.; Bolin, David C. (2006-08-01). "Classification of Actinobacillus spp isolates from horses involved in mare reproductive loss syndrome". American Journal of Veterinary Research. 67 (8): 1426–1432. doi:10.2460/ajvr.67.8.1426. ISSN 0002-9645. PMID 16881857.
- 1 2 3 Sternberg, Susanna (1998-01-16). "Isolation of Actinobacillus equuli from the oral cavity of healthy horses and comparison of isolates by restriction enzyme digestion and Pulsed-Field Gel Electrophoresis". Veterinary Microbiology. 59 (2): 147–156. doi:10.1016/S0378-1135(97)00188-0. ISSN 0378-1135. PMID 9549855.
- ↑ Borges, Alexandre Secorun; Mair, Tim; Pasval, Israel; Saulez, Montague N.; Tennent-Brown, Brett S.; van Eps, Andrew W. (2014-01-01), Orsini, James A.; Divers, Thomas J. (eds.), "Chapter 40 - Emergency Diseases Outside the Continental United States", Equine Emergencies (Fourth Edition), St. Louis: W.B. Saunders, pp. 656–686, ISBN 978-1-4557-0892-5, retrieved 2020-10-28
- ↑ Higgins, Andrew; Snyder, Jack R. (2006). The Equine Manual. Elsevier Saunders. ISBN 9780702027697. Retrieved 2020-10-28.
- 1 2 3 Layman, Quinci D.; Rezabek, Grant B.; Ramachandran, Akhilesh; Love, Brenda C.; Confer, Anthony W. (2014-04-17). "A retrospective study of equine actinobacillosis cases: 1999–2011". Journal of Veterinary Diagnostic Investigation. 26 (3): 365–375. doi:10.1177/1040638714531766. PMID 24742921. S2CID 23285283.
- 1 2 Swedish University of Agricultural Sciences- Faculty of Veterinary Medicine and Agricultural Science. Actinobacillus equuli subsp. equuli. Veterinary bacteriology: information about important bacteria. September 21, 2020. Accessed October 2020. https://www.vetbact.org/?artid=107
- 1 2 3 Huang, Barbara F; Kropinski, Andrew M; Bujold, Adina R; MacInnes, Janet I (2015). "Complete genome sequence of Actinobacillus equuli subspecies equuli ATCC 19392T". Standards in Genomic Sciences. 10: 32. doi:10.1186/s40793-015-0009-x. PMC 4511653. PMID 26203343.
- 1 2 3 4 5 6 7 8 Christensen, H. (2002-09-01). "Reclassification of equine isolates previously reported as Actinobacillus equuli, variants of A. equuli, Actinobacillus suis or Bisgaard taxon 11 and proposal of A. equuli subsp. equuli subsp. nov. and A. equuli subsp. haemolyticus subsp. nov". International Journal of Systematic and Evolutionary Microbiology. 52 (5): 1569–1576. doi:10.1099/ijs.0.01637-0. PMID 12361259.
- ↑ Lauteri, Eleonora; Corsalini, Jacopo; Pepe, Marco; Mandara, Maria Teresa; Passamonti, Fabrizio; Beccati, Francesca (2018-02-01). "EHV-1 Congenital Infection and Concurrent Actinobacillus equuli Septicemia in a Standardbred Neonatal Foal: Clinical, Diagnostic Findings, and Evaluation of Adrenal Gland Function". Journal of Equine Veterinary Science. 61: 7–12. doi:10.1016/j.jevs.2017.10.021. ISSN 0737-0806. S2CID 80442466.
- 1 2 3 Watson, Rachel. "General and Medical Microbiology: Summary of Biochemical Tests". General and Medical Microbiology. Retrieved November 3, 2020.
- ↑ Aryal, Sagar (June 14, 2019). "CAMP Test- Principle, Uses, Procedure and Result Interpretation". Microbiologyinfo.com. Retrieved November 3, 2020.
- ↑ Aryal, Sagar (April 26, 2019). "OF (Oxidation-Fermentation) Test – Principle, Procedure, Uses and Interpretation". Microbiologyinfo.com. Retrieved November 3, 2020.
- 1 2 3 4 Patterson-Kane, J C, J M Donahue, and L R Harrison. "Septicemia and Peritonitis Due to Actinobacillus Equuli Infection in an Adult Horse." Veterinary Pathology 38.2 (2001): 230-232. Web
- ↑ Nielsen et al., 2008, M.K. Nielsen, D.S. Peterson, J. Monrad, S.T. Thamsborg, S.N. Olsen, R.M.Kaplan, Detection and semi-quantification of Strongylus vulgaris DNA in equine faeces by real-time PCR Int. J. Parasitol., 38 (2008), pp. 443-453
- ↑ Kuhnert, P; Berthoud, H; Straub, R; Frey, J (2003-03-20). "Host cell specific activity of RTX toxins from haemolytic Actinobacillus equuli and Actinobacillus suis". Veterinary Microbiology. 92 (1): 161–167. doi:10.1016/S0378-1135(02)00353-X. ISSN 0378-1135. PMID 12488079.
- 1 2 3 4 5 6 7 8 9 10 11 12 Maul, Christiane; Suchowski, Marcel; Klose, Kristin; Antov, Vladislav; Pfeffer, Martin; Schwarz, Bernd-Andreas (February 2020). "Detection of Actinobacillus equuli ssp. equuli in piglets with purulent polyarthritis and tendovaginitis". Tierärztliche Praxis Ausgabe G: Großtiere / Nutztiere (in German). 48 (1): 51–58. doi:10.1055/a-1067-3908. ISSN 1434-1220. PMID 32059237. S2CID 211121771.
- 1 2 Benavente, C. E., and I. C. Fuentealba. "Actinobacillus Suis and Actinobacillus Equuli, Emergent Pathogens of Septic Embolic Nephritis, a New Challenge for the Swine Industry." Archivos De Medicina Veterinaria 44.2 (2012): 99-107. Web.
- 1 2 3 Matthews, S, Dart, Aj, Dowling, Ba, Hodgson, Jl, and Hodgson, Dr. "Peritonitis Associated with Actinobacillus Equuli in Horses: 51 Cases." Australian Veterinary Journal 79.8 (2001): 536-39. Web.
- 1 2 3 Lauteri, Eleonora, Jacopo Corsalini, Marco Pepe, Maria Teresa Mandara, Fabrizio Passamonti, and Francesca Beccati. "EHV-1 Congenital Infection and Concurrent Actinobacillus Equuli Septicemia in a Standardbred Neonatal Foal: Clinical, Diagnostic Findings, and Evaluation of Adrenal Gland Function." Journal of Equine Veterinary Science 61 (2018): 7-12. Web.
- ↑ Pasma, Tim; Postey, Rosemary C.; Snider, Tim; Thompson, Amy B. (November 2010). "Actinobacillus equuli as a primary pathogen in breeding sows and piglets". Can Vet J. 51 (11): 1223–1225. PMC 2957028. PMID 21286321 – via PubMed Central.
- ↑ Mohan, K.; Muvavarirwa, P.; Pawandiwa, A. (1997). "Strains of Actinobacillus spp. from diseases of animals and ostriches in Zimbabwe". The Onderstepoort Journal of Veterinary Research. hdl:2263/20751. ISSN 0030-2465.
- ↑ Berthoud, H., J. Frey, S. Sternberg, R. Straub, and P. Kuhnert. "Antibodies to Aqx Toxin of Actinobacillus Equuli in Horses and Foals." The Veterinary Record 155.8 (2004): 231-233. Web.
- ↑ Sternberg, Susanna; Brändström, Boel (1999-03-31). "Biochemical fingerprinting and ribotyping of isolates of Actinobacillus equuli from healthy and diseased horses". Veterinary Microbiology. 66 (1): 53–65. doi:10.1016/S0378-1135(98)00303-4. ISSN 0378-1135. PMID 10223322.
- ↑ Rycroft, A., Woldeselassie, Gordon, and Bjomson. "Serum Antibody in Equine Neonatal Septicaemia Due to Actinobacillus Equuli." Veterinary Record 143.9 (1998): 254-255. Web.
- ↑ Gay1, C.C.; Lording, P.M. (1980). "Peritonitis in Horses Associated with Actinobacillus equuli". Australian Veterinary Journal. 56 (6): 296–300. doi:10.1111/j.1751-0813.1980.tb05727.x. PMID 7425990. Retrieved November 30, 2020.
{{cite journal}}: CS1 maint: numeric names: authors list (link) - ↑ Castagnetti, C., M. Rossi, F. Parmeggiani, R. G. Zanoni, A. Pirrone, and J. Mariella. "Facial Cellulitis Due to Actinobacillus Equuli Infection in a Neonatal Foal." Veterinary Record 162.11 (2008): 347-349. Web.
- ↑ Peel, M. M.; Hornidge, K. A.; Luppino, M.; Stacpoole, A. M.; Weaver, R. E. (November 1991). "Actinobacillus spp. and related bacteria in infected wounds of humans bitten by horses and sheep". Journal of Clinical Microbiology. 29 (11): 2535–2538. doi:10.1128/JCM.29.11.2535-2538.1991. ISSN 0095-1137. PMC 270368. PMID 1774260.
- ↑ Ashhurst-Smith, Christopher; Norton, Robert; Thoreau, Wendy; Peel, Margaret M. (1998-09-01). "Actinobacillus equuli Septicemia: an Unusual Zoonotic Infection". Journal of Clinical Microbiology. 36 (9): 2789–2790. doi:10.1128/JCM.36.9.2789-2790.1998. ISSN 0095-1137. PMC 105212. PMID 9705442.
- ↑ Elad, Daniel & Shlomovitz, Sara & Lampert, Meir & Yakobson, Boris & Perl, Samuel & Hermelin, Alon. (1988). Actinobacillus equuli in a foal - first report in Israel. Israel Journal of Veterinary Medicine. 44. 261.
- ↑ Weiermayer, Petra. "Wound Healing Disorder in a Horse, Associated With Antimicrobial-Resistant Bacteria, Resolved With a Homeopathic Medicine - A Case Report." Journal of Equine Veterinary Science 67 (2018): 37-43. Web.